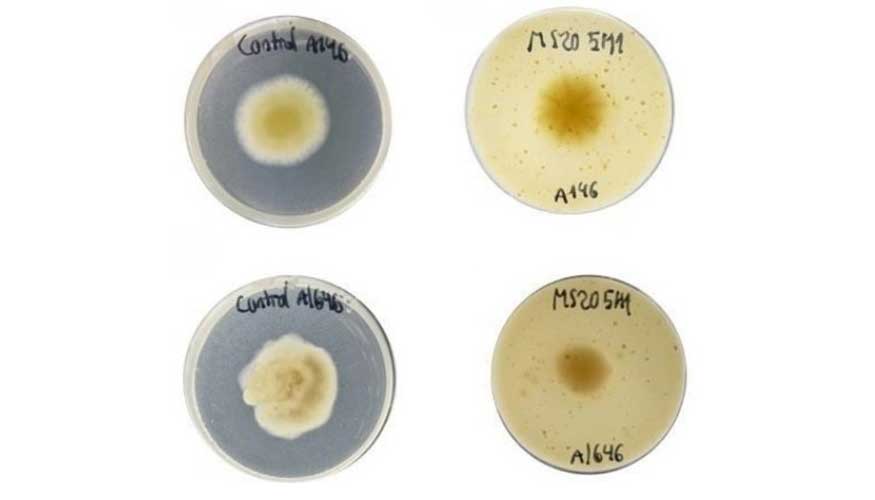
Imagen

Envases fabricados con residuos de arroz para alargar la vida útil de los alimentos cárnicos
La Conselleria de Innovación, Industria, Comercio y Turismo de la Generalitat Valenciana financia la valorización de residuos generados en la industria del arroz con el fin de transformarlos en compuestos bioactivos y celulosa, dos materiales de útil aplicación para la creación de envases activos y aprovechables en la industria cárnica.
El principal objetivo de esta iniciativa es modificar los componentes propios de los envases de plástico, difíciles de reciclar, por materiales sostenibles que optimicen y amplíen la conservación de los alimentos. De esta manera, se alinea con los principios de la economía circular que impulsa la Comisión Europea.
El Laboratorio de Biotecnología Agroalimentaria de la Universitat de València (UV) impulsa este proyecto de valorización de los resultados de investigación hacia las empresas, denominado Actiurròs, en colaboración con el centro tecnológico del plástico, Aimplas. Además, cuenta con financiación de la Unión Europea en el marco del programa FEDER Comunitat Valenciana para el periodo 2021-2027.
Se trata de una solución innovadora que combina sostenibilidad, funcionalidad y circularidad. A diferencia de los envases convencionales para productos cárnicos, que suelen estar compuestos por estructuras multicapa con materiales que dificultan su reutilización, Actiurròs desarrolla un envase 100% compostable en condiciones domésticas, lo que elimina por completo el uso de materiales no reciclables.
Además, contiene compuestos bioactivos naturales obtenidos a partir de la fermentación de residuos del arroz que prolongan la vida útil de los alimentos y reducen, por tanto, el desperdicio. En este sentido, el proyecto presenta un claro enfoque circular, ya que se aprovecha residuos agrícolas locales como materias primas y reduce la huella ambiental del sistema de envasado alimentario.
Dos fases de desarrollo
Para desarrollar este nuevo envase activo se ha de completar un proceso complejo que se divide en distintas etapas. La primera consiste en la fermentación de los residuos de la industria arrocera a partir de bacterias ácido-lácticas, microorganismos que se caracterizan por su capacidad de fermentar azúcares y obtener compuestos con propiedades especiales. Para protegerlos frente a la degradación causada por el calor, estos compuestos se encapsulan, lo que garantiza una mayor efectividad en la conservación de los alimentos.
De manera paralela, se ha extraído celulosa de la paja de arroz con el fin de desarrollar un nuevo biopolímero compostable, un compuesto de origen biológico creado a partir de recursos renovables. Este nuevo bioplástico presenta propiedades de barrera al oxígeno, lo que facilitará su uso en el sector de los envases y embalajes.
De hecho, el objetivo es diseñar, en una segunda fase, un nuevo envase activo para productos cárnicos a partir de la combinación de una base celulosa y compuestos bioactivos. Este envase se procesará mediante una técnica de extrusión por recubrimiento para mejorar las propiedades del producto final, tales como su resistencia al agua o durabilidad.
El nuevo material permitirá sustituir las estructuras multicapa no reciclables, que habitualmente se introducen en los envases cárnicos, por alternativas sostenibles. Es más, contribuirá a extender hasta en un 25% la vida útil de los productos cárnicos frescos, lo que se traducirá en una reducción del desperdicio alimentario estimada en un 5%.

La iniciativa concluirá con la transferencia de los resultados del proyecto tanto a las empresas productoras de arroz como a las fabricantes de envases y distribuidoras de productos cárnicos, fomentando así la adopción de soluciones sostenibles en toda la cadena de valor.
Las estrategias de Actiurròs no solo facilitan la gestión de residuos y ayudan a mejorar la sostenibilidad de los sistemas de envasado, gracias a la sustitución de envases multicapa por materiales biodegradables.
La aplicación de compuestos bioactivos de origen natural también optimiza la conservación de los alimentos sin necesidad de añadir sustancias sintéticas, lo que favorece la calidad y seguridad de los productos. De esta manera, se promueve un modelo de producción circular y respetuoso con el medio ambiente que convierte los residuos agrícolas en soluciones de alto valor añadido.


















